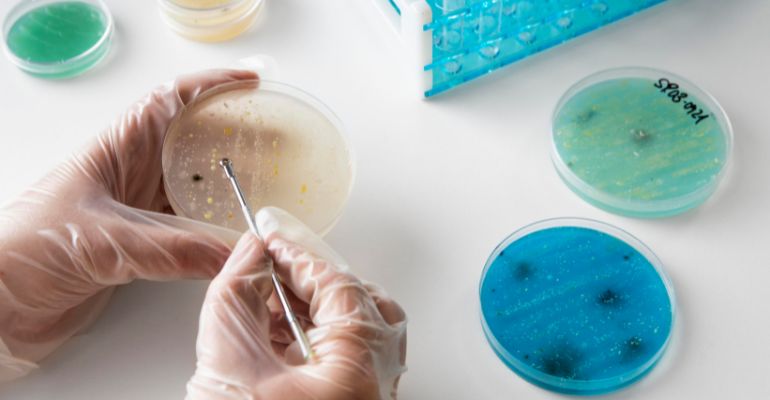
Acesso a saúde: Illumina lança iniciativa para sequenciamento de patógenos em países de baixa renda

A Illumina,empresa global em sequenciamento de DNA, anunciou o lançamento da Iniciativa de Acesso Global à Saúde para apoiar o acesso a ferramentas de sequenciamento de patógenos para a saúde pública em países de baixa e média renda (PBMR). O programa, desenvolvido com orientação de clientes, financiadores e facilitadores de mercado, incluindo a organização sem fins lucrativos FIND, fornecerá estruturas de preços reduzidos para produtos de sequenciamento da Illumina a entidades qualificadas de financiamento global em saúde e abordará desafios-chave de logística internacional e cadeia de suprimentos.
“Sabemos que permitir que os países realizem o sequenciamento de patógenos localmente fortalece os sistemas de saúde, possibilita uma melhor preparação e capacita os países a gerenciar suas ameaças de saúde prioritárias”, disse Vanessa Moeder, chefe de Saúde Global da Illumina. “Isso também evita o envio caro e demorado de amostras para o exterior e leva a tempos de resposta mais rápidos. Não podemos perder tempo nos preparando para a próxima pandemia, e a adoção da vigilância genômica de patógenos em cada país nos permite antecipar ameaças infecciosas.”
Atualmente, os preços de instrumentos e consumíveis de sequenciamento podem variar por país ou região, o que é desafiador para financiadores e doadores e pode limitar a implementação abrangente. Na experiência da equipe global da Illumina, Moeder diz que os países ou regiões cuja preparação de saúde pública mais se beneficiaria da genômica muitas vezes carecem dos recursos para implementá-la de maneira sustentável.
Para começar a abordar esses desafios, a Iniciativa de Acesso Global à Saúde da Illumina oferecerá preços com desconto para uma variedade de aplicações de sequenciamento, incluindo o perfil de resistência a medicamentos na tuberculose, o sequenciamento completo do genoma de vírus emergentes e reemergentes para monitorar a evolução do vírus e apoiar a resposta a surtos, detecção abrangente de patógenos respiratórios para vigilância de doenças semelhantes à gripe, aplicações de vigilância de águas residuais e outras aplicações ambientais para rastrear patógenos e resistências antimicrobianas em nível populacional.
Para simplificar o orçamento e a aquisição, os principais componentes da Illumina para essas aplicações estão disponíveis como kits de combinação de um único número de peça, abrangendo reagentes de preparação de bibliotecas, reagentes de sequenciamento e ferramentas de análise de dados.
Expandir as capacidades de sequenciamento em PBMR é um foco de longo prazo da Illumina e faz parte da base de colaborações com organizações como FIND e o Fundo Global de Luta contra a AIDS, Tuberculose e Malária. Recentemente, avanços significativos foram feitos na capacidade global de sequenciamento genômico: até dezembro de 2022, 84% dos estados membros da Organização Mundial da Saúde (OMS) são capazes de sequenciar o SARS-COV-2, e até outubro de 2023, mais de 16 milhões de genomas do SARS-CoV-2 foram depositados no repositório GISAID. No entanto, disparidades geográficas na capacidade de monitorar patógenos além do SARS-CoV-2 levam a lacunas significativas na detecção de ameaças emergentes, colocando a segurança da saúde global em risco.
“Uma capacidade significativa de sequenciamento foi construída globalmente durante a pandemia para identificar, rastrear e monitorar variantes, capacidade que deve ser aproveitada para ajudar a combater vários desafios de saúde. Iniciativas como esta são cruciais para melhorar a acessibilidade e o acesso à genômica em países de baixa e média renda, garantindo que cada país possa se beneficiar da tecnologia de maneira escalável e sustentável para uso rotineiro”, disse Anita Suresh, Chefe de Genômica e Sequenciamento da FIND.
A estratégia global de vigilância genômica de patógenos da OMS e o guia para implementação nacional de genômica reconhecem ambos que o sequenciamento de patógenos é uma ferramenta única e essencial para impulsionar a preparação para ameaças emergentes e reemergentes, além de aumentar a compreensão da epidemiologia molecular de surtos de doenças. A organização também emitiu uma comunicação rápida destacando como o sequenciamento pode auxiliar no manejo de doenças endêmicas, incluindo tuberculose resistente a medicamentos, uma crise contínua de saúde pública. A genômica recentemente foi utilizada para detectar a introdução de genótipos do vírus da dengue tipo 3 no Brasil, o que tem importantes implicações para a saúde pública, e estudos recentes citam o sequenciamento genômico de patógenos como uma ferramenta crucial para o manejo de surtos como o vírus Marburg, o vírus Ebola e o mpox, bem como parte de uma abordagem de “Saúde Única” para o manejo da resistência antimicrobiana.
“Em uma era em que a tecnologia desempenha um papel crucial na vigilância e diagnóstico durante pandemias, garantir acesso equitativo a essas ferramentas não é apenas uma questão de justiça, mas uma questão de segurança global da saúde pública”, disse Toni Whistler, delegada dos Centros de Controle de Doenças dos EUA para o Fundo Global. “A capacidade de monitorar e diagnosticar doenças de maneira rápida e precisa, sem deixar populações vulneráveis para trás, é fundamental para a nossa preparação coletiva diante de crises globais de saúde. O programa de acesso equitativo desenvolvido e operacionalizado pela Illumina permitirá que muitas nações de baixa e média renda participem do futuro da genômica em saúde pública e preparação.”